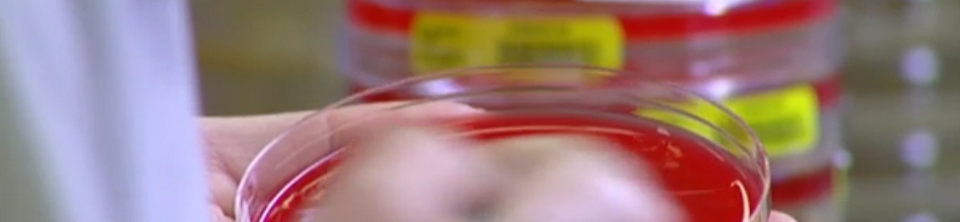

Contact 06 10 13 06 18
Heldere teksen
Uitbraak Klebsiella darmbacterie De Riethorst Stromenland
BRANDPUNT
Bacterie zonder vijand, reportage uit uitzending Brandpunt 08 december 2013
OMROEP BRABANT
NOS
http://nos.nl/video/577823-voorzorgsmaatregelen-onvoldoende-gebleken.html
http://nos.nl/audio/577646-we-hebben-geen-werkzame-antibiotica.html
http://nos.nl/artikel/577623-gevaarlijke-bacterie-in-brabant.html
SBS
http://www.hartvannederland.nl/nederland/noord-brabant/2013/klebsiella-uitbraak-in-verpleeghuis/
BN DE STEM
OVERIG
http://www.radio1.nl/item/167370-We%20hebben%20geen%20werkzame%20antibiotica.html
http://www.nieuws.nl/algemeen/20131121/Uitbraak-klebsiella-in-Brabants-verpleeghuis
http://www.nationalezorggids.nl/ziekenhuizen/nieuws/18397-uitbraak-darmbacterie-klebsiella-in-verpleeghuis-brabant.html
http://www.rtlnieuws.nl/nieuws/binnenland/uitbraak-gevaarlijke-klebsiella-bacterie-tehuis
http://www.dichtbij.nl/breda/regio/artikel/3202322/uitbraak-gevaarlijke-bacterie-in-tehuis-geertruidenberg.aspx
http://www.nu.nl/gezondheid/3634686/uitbraak-klebsiella-in-tehuis-geertruidenberg.html
http://eropuit.blog.nl/sport-gezondheid/2013/11/21/gevaarlijke-darmbacterie-brabant
https://mobile.twitter.com/_waalwijk
http://www.medischnieuwstrc.com/uitbraak-darmbacterie-klebsiella-in-verpleeghuis-brabant/
E-mail info@tactcommunicatie.nl
